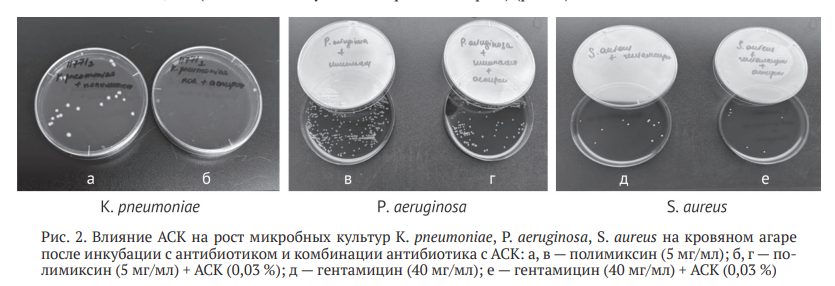

11.03.2026
11.03.2026
Перспективы применения ацетилсалициловой кислоты в комбинации с антибактериальными препаратами против ведущих возбудителей остеомиелита
Ацетилсалициловая кислота (АСК) — один из перспективных кандидатов для усиления действия антибактериальных препаратов
ВВЕДЕНИЕ
Остеомиелит — тяжелое инфекционно-воспалительное заболевание костной ткани, вызываемое преимущественно бактериальными возбудителями, такими как Staphylococcus aureus, Pseudomonas aeruginosa, и другими патогенами [1–4]. Несмотря на достижения современной антимикробной терапии, лечение пациентов с остеомиелитом остается сложной задачей из-за формирования биоплёнок, устойчивости к антибиотикам и хронизации воспалительного процесса [5–7].
В связи с этим, актуальным направлением является поиск новых стратегий терапии, включающих комбинацию антибактериальных препаратов с адъювантными средствами, способными усиливать их эффективность.
Ацетилсалициловая кислота (АСК) — один из перспективных кандидатов для усиления действия антибактериальных препаратов. Помимо известного противовоспалительного и антиагрегантного действия, аспирин демонстрирует способность модулировать активность антибиотиков, подавлять образование бактериальных биопленок и влиять на иммунный ответ [8–11].
Цель работы — оценить in vitro влияние аспирина в комбинации с антибактериальными препаратами на рост микробных культур клинически значимых штаммов бактерий при остеомиелите.
В последние годы появляются данные о его синергизме с некоторыми антибактериальными препаратами в отношении устойчивых штаммов микроорганизмов [12].
МАТЕРИАЛЫ И МЕТОДЫ
Объект исследования — клинически значимые штаммы бактерий K. pneumoniae (n = 12), P. aeruginosa (n = 12), S. aureus (n = 12), S. epidermidis (n = 12), выделенные из ран пациентов c хроническим остеомиелитом.
Исследование биоматериалов, полученных от пациентов, выполняли в соответствии с принятыми международными стандартами (UK SMI). Видовую идентификацию микробных культур проводили методом MALDI-TOF масс-спектрометрии. Чувствительность бактерий к антимикробным препаратам (K. pneumoniae — к ципрофлоксацину, цефепиму, имипенему, меропенему; P. aeruginosa — к ципрофлоксацину, цефепиму, имипенему, меропенему, амикацину, пиперациллин/тазобактаму; S. aureus и S. epidermidis — к ванкомицину, гентамицину, ципрофлоксацину, эритромицину, цефокситину), включенным в формулярный перечень Центра, определяли согласно критериям EUCAST (англ.: European Committee on Antimicrobial Susceptibility Testing, Version 9.0, valid from 2019-01-01).
Критерий включения: клинические штаммы в пределах одной таксономической группы, характеризовавшиеся сходной чувствительностью к тестируемым антибактериальным препаратам.
В эксперимент вошли только метициллин-чувствительные штаммы стафилококков.
В качестве тест-культур использовали музейные штаммы бактерий, принадлежащих к четырем таксономическим группам: Pseudomonas aeruginosa АТСС 27853, Klebsiella pneumoniae АТСС 700603, Staphylococcus aureus АТСС 29213, Staphylococcus epidermidis АТСС 14990.
Эксперимент разделен на четыре серии:
— контрольная серия — готовили суспензии исследуемых культур, содержащие 5×106 КОЕ/мл (колониеобразующие единицы) бактерий;
— вторая серия (0,03 % АСК, 300 мкг/мл) — во второй части эксперимента по 1 мл АСК вносили в пробирки с культурами, содержащими 5×106 КОЕ/мл бактерий, инкубировали при комнатной температуре в течение 30 мин;
— третья серия — полимиксин (5 мг/мл) в случае с грамотрицательными бактериями и гентамицин (40 мг/мл) в случае с грамположительными бактериями инкубировали при комнатной температуре в течение 30 мин совместно с суспензиями, содержащими 5×106 КОЕ/мл микробных клеток;
— четвертая серия — суспензии бактерий (5×106 КОЕ/мл) инкубировали с комбинацией АСК (0,05 %) с антибиотиками (полимиксином или гентамицином) в течение 30 мин.
Полимиксин обладает активностью против устойчивых грамотрицательных бактерий (P. aeruginosa, A. baumannii, K. pneumoniae, E. coli), является препаратом выбора для лечения инфекций, вызванных бактериями с резистентностью к карбапенемам.
Полимиксины действуют путем разрушения внешней мембраны грамотрицательных бактерий (выступая в роли детергента). Гентамицин обладает высокой бактерицидной активностью в отношении стафилококков.
Для получения газона микробные взвеси в каждой серии эксперимента с помощью ватного тампона наносили на поверхность агара Мюллера – Хинтон, на поверхность которого помещали диски с антибиотиками и инкубировали в течение суток в термостате при 37°. Одновременно делали высевы на агар Шедлера с бараньей кровью (с гемином и витамином К1) для учета роста микробных клеток. Результаты оценивали через сутки.
Антибактериальное действие оценивали по отсутствию зоны роста бактерий вокруг дисков.
Все эксперименты проводили в трёх повторах, данные представлены в виде среднего арифметического значения (М) и стандартного отклонения (SD). Статистические тесты выполнены в программе Gnumeric 1.12.17.
Cравнение групп проводили с помощью критерия Стьюдента после предварительного определения типа распределения в выборках с помощью критерия Андерсона – Дарлинга. Порог значимости для всех тестов составлял р < 0,05.
Работа выполнена в формате in vitro исследования без участия животных или человека.
РЕЗУЛЬТАТЫ
При совместной инкубации АСК (0,05 %) с грамотрицательными бактериями (K. pneumoniae, P. aeruginosa) на чашках Петри отсутствовал рост микроорганизмов. В случае с бактериями S. aureus количество КОЕ было снижено в сравнении с контрольной группой. На чашках с S. epidermidis рост отсутствовал (рис. 1).

При совместной инкубации полимиксина с P. aeruginosa на чашках Петри регистрировали незначительный рост бактерий, в случае с K. pneumoniae наблюдали лишь отдельные колонии.
При инкубации совместно с полимиксином и АСК (0,03 %) на чашках с K. pneumoniae роста микроорганизмов не было, на чашках с P. aeruginosa отмечали незначительный рост.
Гентамицин подавлял рост бактерий S. aureus (на чашках отмечали незначительное количество бактерий). АСК (0,03 %) усиливал бактерицидные свойства гентамицина (на чашках отсутствовал рост бактерий) (рис. 2).
Также наблюдали различия в зонах задержки роста бактерий при постановке антибиотикочувствительности в зависимости от концентрации АСК (рис. 3, б, в). Для штаммов K. pneumomiae при использовании АСК (0,03 %) зоны задержки роста бактерий не отличались от контрольной группы, однако число жизнеспособных клеток на поверхности агара было ниже (рис. 3, д).

В группе с АСК значимые различия в зонах задержки роста наблюдали для клиндамицина и цефокситина в сравнении с контрольной серией для клинических штаммов S. aureus (табл. 1).
Для штаммов S. epidermidis отмечены отличия в зоне задержки роста бактерий для клиндамицина (табл. 2). На чашках с P. aeruginosa значимые изменения в зонах задержки роста наблюдали для имипенема, меропенема, цефепима и ципрфлоксацина (табл. 3).

ОБСУЖДЕНИЕ
Нестероидные противовоспалительные средства (НПВС) традиционно применяют в качестве противовоспалительных, болеутоляющих и жаропонижающих препаратов. Вместе с тем, имеются данные о воздействия НПВС на бактерии и связанные с ними инфекции [13]. Данные об активности НПВП in vitro против планктонных бактерий и биоплёнок на сегодняшний день противоречивы [14–17]. Один из представителей НПВС — ацетилсалициловая кислота, являющаяся синтетическим производным салициловой кислоты.
Действие АСК — комплексное, зависит от дозировки. Противовоспалительное, жаропонижающее и обезболивающее (используются средние/высокие дозы ~ 500–1000 мг) действия реализуются через ингибирование ферментов циклооксигеназ (ЦОГ-1 и ЦОГ-2), которые участвуют в синтезе простагландинов, — веществ, вызывающих боль и отек при воспалении; антиагрегантное (используются низкие дозы ~ 75–100 мг.) действие реализуется через блокаду ЦОГ-1 в тромбоцитах.
В разных исследованиях приведены данные о влиянии АСК на тромбоциты после воздействия бактериями (Staphylococcus aureus, Enterococcus faecalis, Streptococcus pyogenes, Escherichia coli) [18, 19]. Показано, что клинические штаммы S. aureus могут вызывать активацию тромбоцитов, экспрессию маркеров клеточной гибели и высвобождение факторов воспаления [18, 19].
Ацетилсалициловая кислота ограничивает воздействие S. aureus на тромбоциты, снижая темпы гибели клеток, восстанавливает их количество и уменьшая вклад тромбоцитов в воспаление, связанное с присутствием в крови бактериальных патогенов.
В настоящее время изучают способность аспирина оказывать влияние на образование биопленок микроорганизмами; проявлять синергизм с антибиотиками, повышая проницаемость клеточных стенок бактерий и делая их более уязвимыми; модулировать иммунный ответ организма [8–12]. L.I. Kupferwasser et al. сделали вывод об усилении чувствительности MRSA к ß-лактамным антибиотикам в присутствии аспирина [9]. В другой работе показано усиление активности ванкомицина против устойчивых энтерококков в присутствии аспирина [20]. В ряде исследований приводятся данные о бактериостатическом действии АСК на грамположительные бактерии и отсутствие эффекта при воздействии на грамотрицательные бактерии [13]. S.A. El-Mowafy et al. при исследовании QS-ингибирующее действия АСК на P. aeruginosa наблюдали снижение подвижности бактерий [21]. В другом исследовании показали, что воздействие АСК в течение 1,5 часов приводило к удалению 30 % биоплёнок, образованных S. Epidermidis и P. aeruginosa на полистироле [22].
В литературе имеются данные, свидетельствующие о формировании устойчивых популяций бактерий после воздействия НПВП, в том числе и АСК [14, 23].
В нашем исследовании отсутствие роста на чашке c бактериями S. epidermidis в присутствии АСК, даже без антибиотиков, позволяет предположить, что одним из механизмов действия может быть подавление адгезии и формирования биоплёнки [24]. Наличие выраженного эффекта АСК в отношении грамотрицательных бактерий (K. pneumoniae, P. aeruginosa) может быть связано с его воздействием на наружную мембрану микробных клеток, в то время как на грамположительные бактерии (S. aureus) препарат оказывал меньшее влияние, лишь снижая метаболическую активность. Аспирин, будучи слабой кислотой, также может нарушать целостность мембран и повышать их проницаемость [8].
Наши результаты позволяют предположить, что АСК усиливает действие полимиксина. Усиление бактерицидного действия гентамицина в присутствии АСК на S. aureus может быть связано со способностью салицилатов подавлять синтез белка и нарушать энергетический метаболизм бактерий, что повышает эффективность накопления аминогликозидов внутри клетки [13]. Данное исследование носит больше описательный характер. В перспективе планируется определение индексов МИК (минимальная ингибирующая концентрация) и FIC (фракционная ингибирующая концентрация) для подтверждения синергизма, изучение влияния АСК на зрелые биоплёнки и оценка эффективности комбинации на соответствующих in vivo моделях остеомиелита.
ЗАКЛЮЧЕНИЕ
Исследование продемонстрировало, что ацетилсалициловая кислота in vitro проявляет синергизм с рядом антибиотиков, значительно усиливая их бактерицидную активность в отношении клинических изолятов, ассоциированных с остеомиелитом.
СПИСОК ИСТОЧНИКОВ
1. Шипицына И.В., Осипова Е.В. Мониторинг ведущей грамположительной микрофлоры и ее антибиотикочувствительности у лиц с хроническим остеомиелитом за трехлетний период. Гений ортопедии. 2022;28(2):189-193. doi: 10.18019/1028-4427- 2022-28-2-189-193.
2. Zhang K, Bai YZ, Liu C, et al. Composition of pathogenic microorganism in chronic osteomyelitis based on metagenomic sequencing and its application value in etiological diagnosis. BMC Microbiol. 2023;23(1):313.
3. Миронов С.П., Цискарашвили А.В., Горбатюк Д.С. Хронический посттравматический остеомиелит как проблема современной травматологии и ортопедии (обзор литературы).
4. Шипицына И.В., Осипова Е.В., Леончук Д.С., Судницын А.С. Мониторинг ведущей грамотрицательной микрофлоры и антибиотикорезистентности при остеомиелите.
5. Савилов Е.Д., Анганова Е.В., Носкова О.А., Духанина А.В. Бактериальные биоплёнки при гнойно-септических инфекциях. Acta biomedica scientific. 2019;4(5):38-42. doi: 10.29413/ABS.2019-4.5.6.
6. Гордина Е.М., Божкова С.А. Бактериальные биопленки в ортопедии: проблема и возможные перспективы профилактики. РМЖ. 2021;(8):29-32.
7. Шипицына И.В., Осипова Е.В. Резистентность ведущих возбудителей хронического остеомиелита. Клиническая лабораторная диагностика. 2022;67(12):723-728. doi: 10.51620/0869-2084-2022-67-12-723-728.
8. Roberge S, Bujold E, Nicolaides KH. Aspirin for the prevention of preterm and term preeclampsia: systematic review and metaanalysis. Am J Obstet Gynecol. 2018;218(3):287-293.e1. doi: 10.1016/j.ajog.2017.11.561.
9. Kupferwasser LI, Yeaman MR, Shapiro SM, et al. Acetylsalicylic acid reduces vegetation bacterial density, hematogenous bacterial dissemination, and frequency of embolic events in experimental Staphylococcus aureus endocarditis through antiplatelet and antibacterial effects. Circulation. 1999;99(21):2791-2797.
10. Amin, Sawsan M.; Ahmed, Insan M.; and Abed, Ahmed N. Аntibacterial effect of acetylsalicylic acid on the efficiency of azithromycin against resistant Salmonella enterica: an in vitro study. Baghdad Sci J. 2025;22:(7): 2254-2263.
11. Sekar A, Gil D, Tierney P, et al. Synergistic use of anti-inflammatory ketorolac and gentamicin to target staphylococcal biofilms. J Transl Med. 2024;22(1):102. doi: 10.1186/s12967-024-04871-y.
12. Gil D, Daffinee K, Friedman R, et al. Synergistic antibacterial effects of analgesics and antibiotics against Staphylococcus aureus. Diagn Microbiol Infect Dis. 2020;96(4):114967. doi: 10.1016/j.diagmicrobio.2019.114967.
13. Di Bella S, Luzzati R, Principe L, et al. Aspirin and Infection: A Narrative Review. Biomedicines. 2022;10(2):263. doi: 10.3390/ biomedicines10020263.
14. Belfield K, Bayston R, Hajduk N, et al. Evaluation of combinations of putative anti-biofilm agents and antibiotics to eradicate biofilms of Staphylococcus aureus and Pseudomonas aeruginosa. J Antimicrob Chemother. 2017;72(9)
15. Abbas HA, Atallah H, El-Sayed MA, El-Ganiny AM. Diclofenac mitigates virulence of multidrug-resistant Staphylococcus aureus. Arch Microbiol. 2020;202(10):2751-2760.
16. Gerner E, Almqvist S, Werthén M, Trobos M. Sodium salicylate interferes with quorum-sensing-regulated virulence in chronic wound isolates of Pseudomonas aeruginosa in simulated wound fluid. J Med Microbiol. 2020;69(5):767-780. doi: 10.1099/jmm.0.001188.
17. Leão C, Borges A, Simões M. NSAIDs as a Drug Repurposing Strategy for Biofilm Control. Antibiotics (Basel). 2020;9(9):591. doi: 10.3390/ antibiotics9090591.
18. Hannachi N, Baudoin JP, Prasanth A, et al. The distinct effects of aspirin on platelet aggregation induced by infectious bacteria. Platelets. 2020;31(8):1028-1038. doi: 10.1080/09537104.2019.1704717.
19. Chabert A, Damien P, Verhoeven PO, et al. Acetylsalicylic acid differentially limits the activation and expression of cell death markers in human platelets exposed to Staphylococcus aureus strains. Sci Rep. 2017;7(1):5610. doi: 10.1038/s41598-017-06024-2.
20. Sieradzki K, Tomasz A. Inhibition of cell wall turnover and autolysis by vancomycin in a highly vancomycin-resistant mutant of Staphylococcus aureus. J Bacteriol. 1997;179(8):2557-2566. doi: 10.1128/jb.179.8.2557-2566.1997.
21. El-Mowafy SA, Abd El Galil KH, El-Messery SM, Shaaban MI. Aspirin is an efficient inhibitor of quorum sensing, virulence and toxins in Pseudomonas aeruginosa. Microb Pathog. 2014;74:25-32. doi: 10.1016/j.micpath.2014.07.008.
22. Abidi SH, Ahmed K, Kazmi SU. The antibiofilm activity of Acetylsalicylic acid, Mefenamic acid, Acetaminophen against biofilms formed by P. aeruginosa and S. epidermidis. J Pak Med Assoc. 2019;69(10):1493-1495.
23. Verma T, Bhaskarla C, Sadhir I, уе фд. Non-steroidal anti-inflammatory drugs, acetaminophen and ibuprofen, induce phenotypic antibiotic resistance in Escherichia coli: roles of marA and acrB. FEMS Microbiol Lett. 2018;365(22). doi: 10.1093/femsle/fny251.
24. Paes Leme RC, da Silva RB. Antimicrobial Activity of Non-steroidal Anti-inflammatory Drugs on Biofilm: Current Evidence and Potential for Drug Repurposing. Front Microbiol. 2021;12:707629. doi: 10.3389/fmicb.2021.707629.
Информация об авторах:
Ирина Владимировна Шипицына — кандидат биологических наук, ведущий научный сотрудник,
Елена Владимировна Осипова — кандидат биологических наук, старший научный сотрудник,
Шастов Александр Леонидович — кандидат медицинских наук, старший научный сотрудник
Теги: хронический остеомиелит
234567 Начало активности (дата): 11.03.2026
234567 Кем создан (ID): 989
234567 Ключевые слова: ацетилсалициловая кислота, хронический остеомиелит, S. aureus, S. epidermidis, K. pneumoniae, P. aeruginosa
12354567899
Похожие статьи
Хронический посттравматический остеомиелит как проблема современной травматологии и ортопедии (обзор литературы)Рентген на дому 8 495 22 555 6 8
Хронический посттравматический остеомиелит как проблема современной травматологии и ортопедии
«Многоликий» хронический остеомиелит: лучевая диагностика
Хронический посттравматический остеомиелит трубчатых костей



